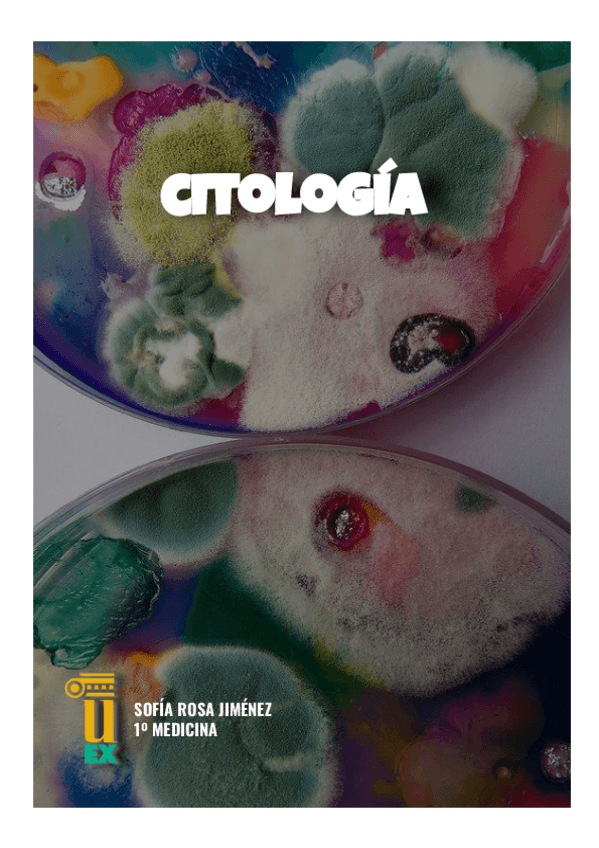
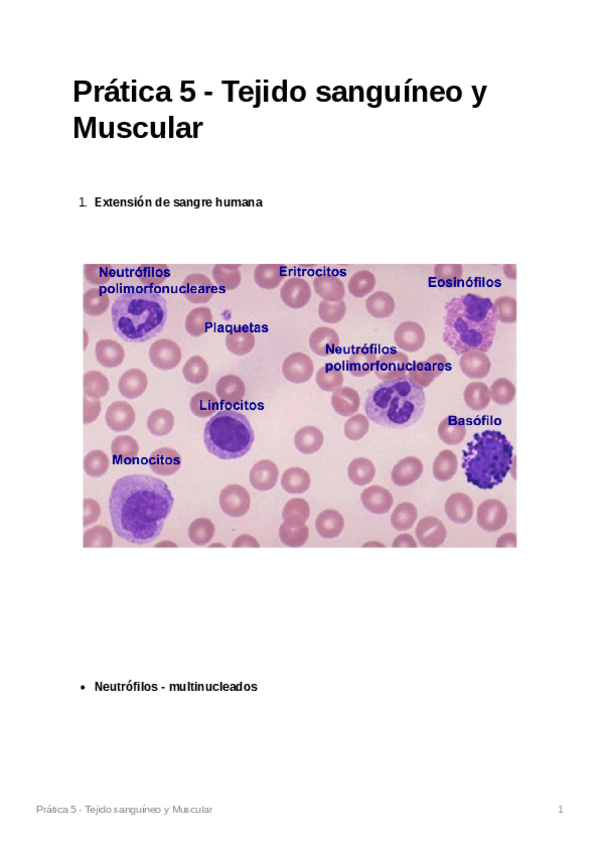

Citología e Histología General Humana
He publicado nuevos apuntes de 1º Citología e Histología General Humana: ORGANOGRAFIA-CURSO-2025-2026.docx
He publicado nuevos apuntes de 1º Citología e Histología General Humana: CITOLOGIA-1o-PARTE.docx
apuntes
-
Prácticas Citología e Histología General Humana
He publicado nuevos apuntes de 1º Citología e Histología General Humana: Prácticas Citología e Histología General Humana
apuntes
-
Temas Citología e Histología General Humana
Las fotos de las prácticas las tenéis en otra carpeta :)
PLAN NUEVO HISTOLOGÍA PARTE 1, siento tener que dividirlo en dos partes, sino no me dejaba subirlo con buena calidad. Ambas partes y organografía están enumeradas.
BLOQUE NUEVO DE ORGANOGRAFÍA, plan nuevo medicina 2025. Perdón por tener que dividirlo en dos partes, están enumeradas las páginas de modo que primero va histología y luego organografía. Espero que os sirva
He publicado nuevos apuntes de 1º Citología e Histología General Humana: Organografia-UEX.pdf
He publicado nuevos apuntes de 1º Citología e Histología General Humana: Citologia-UEX.pdf
He publicado nuevos apuntes de 1º Citología e Histología General Humana: Histologia-UEX.pdf
He publicado nuevos apuntes de 1º Citología e Histología General Humana: Tema-10-Esquema Tejido-epitelial.pdf.pdf.pdf
He publicado nuevos apuntes de 1º Citología e Histología General Humana: Tema-8-Ciclo-Celular.pdf
He publicado nuevos apuntes de 1º Citología e Histología General Humana: Tema-6-Mitocondria.pdf
He publicado nuevos apuntes de 1º Citología e Histología General Humana: Tema-5-Compartimentos-intracelulares-y-transporte-de-proteinas-II.pdf
He publicado nuevos apuntes de 1º Citología e Histología General Humana: Tema-3-Nucleo-Celular-2.pdf
He publicado nuevos apuntes de 1º Citología e Histología General Humana: Tema-4-compartimentos-Intracelulares-Y-Transporte-De-Proteinas-I.pdf
He publicado nuevos apuntes de 1º Citología e Histología General Humana: Tema-2-Membrana-plasmatica-3.pdf
apuntes
-
Resúmenes citología
He publicado nuevos apuntes de 1º Citología e Histología General Humana: Resúmenes citología
apuntes
-
CITOLOGÍA 2024 - 2025 (UEX)
temario muy completo, esquematizado y con muchos dibujos que facilitan la comprensión
He publicado nuevos apuntes de 1º Citología e Histología General Humana: Apuntes-histologia-1o-medicina-Uex-23-24.pdf
He publicado nuevos examenes de 1º Citología e Histología General Humana: EX-HISTOLOGIA-IMAGENES-DICIEMBRE-2023.pdf
He publicado nuevos practicas de 1º Citología e Histología General Humana: Imagenes-practicas-de-histologia.pdf
He publicado nuevos apuntes de 1º Citología e Histología General Humana: Esquema-glia.pdf
He publicado nuevos apuntes de 1º Citología e Histología General Humana: Esquema-tipos-de-neuronas.pdf
He publicado nuevos apuntes de 1º Citología e Histología General Humana: Practica-5-citologia.pdf
He publicado nuevos apuntes de 1º Citología e Histología General Humana: Practica-4-Histologia.pdf
He publicado nuevos practicas de 1º Citología e Histología General Humana: Praticas-Histologia.pdf
examenes
-
Examenes 2021-2022
He publicado nuevos examenes de 1º Citología e Histología General Humana: Examenes 2021-2022
He publicado nuevos apuntes de 1º Citología e Histología General Humana: Citologia-Sofia-Blanco-Lucas.pdf
He publicado nuevos apuntes de 1º Citología e Histología General Humana: Histologia-Sofia-Blanco-Lucas.pdf
examenes
-
PREGUNTAS CITO E HISTO
He publicado nuevos examenes de 1º Citología e Histología General Humana: PREGUNTAS CITO E HISTO
apuntes
-
Histología - microscopía
Microscopía/histología - med y fisio
He publicado nuevos apuntes de 1º Citología e Histología General Humana: PATOLOGIA.pdf
apuntes
-
Apuntes Citología
He publicado nuevos apuntes de 1º Citología e Histología General Humana: Apuntes Citología
apuntes
-
APUNTES CITOLOGÍA
He publicado nuevos apuntes de 1º Citología e Histología General Humana: APUNTES CITOLOGÍA
apuntes
-
Citología e histología 2020
He publicado nuevos apuntes de 1º Citología e Histología General Humana: Citología e histología 2020
He publicado nuevos apuntes de 1º Citología e Histología General Humana: HISTOLOGIA-2a-parte.pdf
apuntes
-
HISTOLOGÍA 1ª parte
He publicado nuevos apuntes de 1º Citología e Histología General Humana: HISTOLOGÍA 1ª parte
He publicado nuevos apuntes de 1º Citología e Histología General Humana: CITOLOGIA.pdf
apuntes
-
HISTOLOGÍA
He publicado nuevos apuntes de 1º Citología e Histología General Humana: HISTOLOGÍA
test
-
PREGUNTAS HISTOLOGÍA
He publicado nuevos test de 1º Citología e Histología General Humana: PREGUNTAS HISTOLOGÍA
He publicado nuevos test de 1º Citología e Histología General Humana: VERDADERO-FALSO.pdf
test
-
PREGUNTAS CITOLOGÍA
He publicado nuevos test de 1º Citología e Histología General Humana: PREGUNTAS CITOLOGÍA
He publicado nuevos apuntes de 1º Citología e Histología General Humana: IMAGENES-DE-CITOLOGIA.pdf
examenes
-
Exámenes Citología e Histología
He publicado nuevos examenes de 1º Citología e Histología General Humana: Exámenes Citología e Histología
apuntes
-
HISTOLOGÍA 2019/2020
He publicado nuevos apuntes de 1º Citología e Histología General Humana: HISTOLOGÍA 2019/2020
apuntes
-
Imágenes Histología
He publicado nuevos apuntes de 1º Citología e Histología General Humana: Imágenes Histología